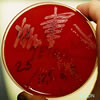

| Bakteriyostatik |
|---|

Bakteriyostatik |
| Bakteri Gelişimi Durduran.Bakterilerin gelişmesini durduran kimyasalların genel adı. Bakteri üzerindeki etki konsantrasyon ve süreye bağlıdır. Ayrıca bakınız; bakterisit. |
| Bakteriyostatik |
|---|
Bakteriyostatik |
| Bakteri Gelişimi Durduran.Bakterilerin gelişmesini durduran kimyasalların genel adı. Bakteri üzerindeki etki konsantrasyon ve süreye bağlıdır. Ayrıca bakınız; bakterisit. |